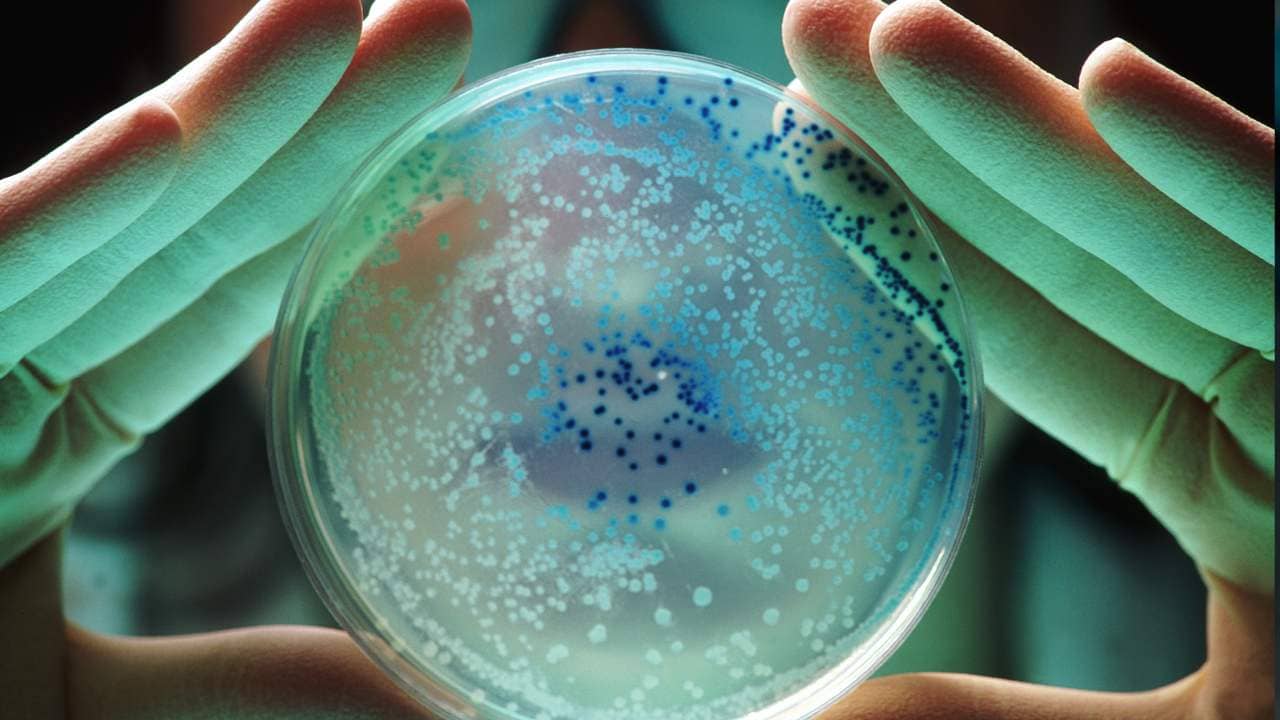
Bengal Leading: বজ্জাত ব্যাকটেরিয়াদের দাপাদাপি ঠেকাতে বিশাল হাব! চিকিৎসা ক্ষেত্রে এবার গোটা দেশকে দিশা দেখাবে বাংলা

ব্যাকটেরিয়া নিয়ে বিপদ চারদিক দিয়ে ঘিরে ফেলেছে। আউটডোরে দেখাতে আসা রোগীরাও রেহাই পাচ্ছেন না। তাঁদের শরীরেও যে দানা বেঁধেছে সুপারবাগ। এই সুপারবাগ আসলে বিপজ্জনক ড্রাগ রেজিট্যান্স ব্যাকটেরিয়ার দল। একটি সমীক্ষা বলছে, দেশে ICU-তে ভর্তি সুপারবাগ সংক্রমিত রোগীদের ৩৮ শতাংশ ১৪ দিনে মারা যায়! তাহলে ভাবুন বিষয়টি কোথায় পৌঁছেছে। আর বিশ্ব স্বাস্থ্য সংস্থার একটি রিপোর্ট বলছে, দুনিয়ার যে দশটি রোগ মানুষের জন্য বিপজ্জনক সেই তালিকায় রয়েছে এএমআর। চিন্তা আরও আছে। শুধু অ্যান্টিবায়োটিকের যথেচ্ছ ব্যবহারই নয়, গবেষকরা বলছেন, বিভিন্ন গবাদি পশু, এবং সবজি, প্রাণী, মাছ, এসব খাবারের মধ্যে দিয়ে নিঃশব্দে শরীরে ঢুকছে ব্যাকটেরিয়া!
বিশেষজ্ঞরা বলছেন, শুধুমাত্র ভারতেই অ্যান্টিবায়োটিক প্রতিরোধী সংক্রমণে মৃত্যু হয় অনেক শিশুর। সচেতন না হলে আগামী কয়েক বছরের মধ্যে এমন সময় আসবে, যখন বেশ কিছু চেনা অ্যান্টিবায়োটিক আর কাজ করবে না শরীরে। অসুখ প্রতিরোধী অ্যান্টিবায়োটিক তার কার্যক্ষমতা হারাবে। শক্তিশালী হয়ে উঠবে জীবাণুরা। এই প্রেক্ষাপটে কতটা তৈরি বাংলা?
ব্যাকটেরিয়ার বিরুদ্ধে বঙ্গ-মডেল!
ব্যাকটেরিয়ার সঙ্গে লড়াইয়ে দেশকে পথ দেখাতে চলেছে বাংলার গবেষণা সংস্থা। দেশের প্রথম জীবাণু সংক্রমণ গবেষণা সংস্থার হাব তৈরি হচ্ছে বাংলায়। নতুন অ্যান্টিবায়োটিকের পাশাপাশি বিকল্প চিকিৎসার সন্ধান দেবে NIRBI ক্লিনিক্যাল ট্রায়ালের মাধ্যমে সমাধানের পথ বার করবে বাংলার গবেষণা প্রতিষ্ঠান। NIRBI হবে দেশের অ্যান্টি মাইক্রোবিয়াল রেজিস্ট্যান্স হাব। দেশ থেকে আসা ব্যাকটেরিয়ার সিকোয়েন্স হবে বাংলায়। কী ধরনের প্যাটার্ন দেখা হবে, হবে স্টোরেজও।